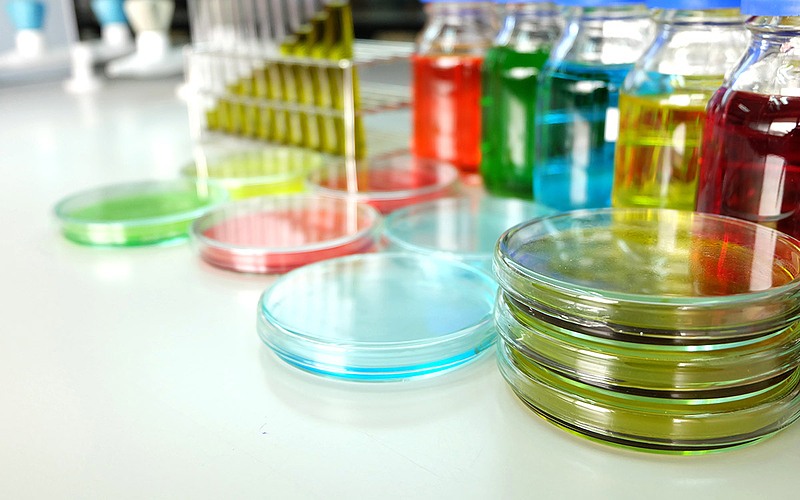
Файл:Teaser news2023 galen2.jpg

Код для вставки картинки в статью:
Размер при предпросмотре: 800 × 500 пикселов
Изображение в более высоком разрешении (1200 × 750 пикселов, размер файла: 166 КБ, MIME-тип: image/jpeg)
История файла
Нажмите на дату/время, чтобы просмотреть, как тогда выглядел файл.
(недавние | старейшие) Просмотреть (более новых 50) (более старых 50) (20 | 50 | 100 | 250 | 500)| Дата/время | Миниатюра | Размер объекта | Участник | Примечание | |
|---|---|---|---|---|---|
| текущий | 09:08, 21 июля 2023 |  | 1200 × 750 (166 КБ) | Avkiparo (вклад) |
- Поиск одинаковых файлов
- Редактировать этот файл, используя внешнюю программу (подробнее см. в руководстве по установке)
Ссылки на файл
Следующая 1 страница ссылается на данный файл:

